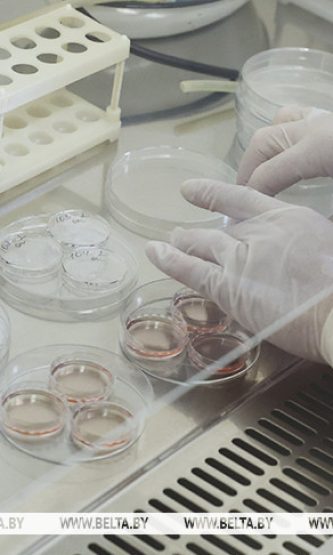

Здоровье - 20.10.2025
В Лепельском районе стартовала вакцинация против

Основы безопасности - 20.10.2025
На контроле ОГАИ

Президент - 20.10.2025
Кадры, большая сделка с США, экономическая

Во исполнение поручения Главы государства по наведению порядка с транспортными средствами, которые создают препятствия для движения на автозаправочных станциях, Министр
Наталья Храповицкая
20.10.2025
Кто обязан платить налог
Физические лица — собственники жилых помещений, получающие доход от их сдачи в аренду, обязаны уплачивать подоходный.

На контроле ОГАИ
Во исполнение поручения Главы государства по наведению порядка с транспортными средствами, которые создают препятствия для движения на автозаправочных станциях, Министр
Редакция
- 20.10.2025

Кадры, большая сделка с США, экономическая
Рабочий график Президента Беларуси всегда весьма насыщен событиями. Александр Лукашенко проводит совещания и рабочие встречи по наиболее актуальным вопросам развития
Редакция
- 20.10.2025



Кто обязан платить налог Физические лица — собственники жилых помещений, получающие доход от их сдачи в аренду, обязаны уплачивать подоходный налог. Это требование действует независимо от наличия или отсутствия договора найма. Сроки уплаты
LIFESTYLESubTitle

Наталья Храповицкая
- Здоровье - 20.10.2025
В Лепельском районе стартовала вакцинация против инфекции, вызванной
В Республике Беларусь началась вакцинация девочек против вируса папилломы человека. Основная цель программ вакцинации против ВПЧ заключается в защите женщин от рака шейки матки, который является наиболее распространенным заболеванием, вызываемым ВПЧ. Возможно, сейчас
TAGS:
Module 14SubTitle

Редакция
- Молодёжное - 17.10.2025
На Лепельщине продолжается акция “Молодежь
В рамках республиканской акции «Молодежь за безопасность» работники Лепельского районного отдела по чрезвычайным

Адвокаты Беларуси проведут бесплатные консультации
Адвокаты всех территориальных коллегий 21 октября проведут акцию по бесплатному консультированию по вопросам
Вторую бесплатную попытку ЭКО могут
В Беларуси с 2026 года могут начать предоставлять вторую бесплатную попытку экстракорпорального оплодотворения.